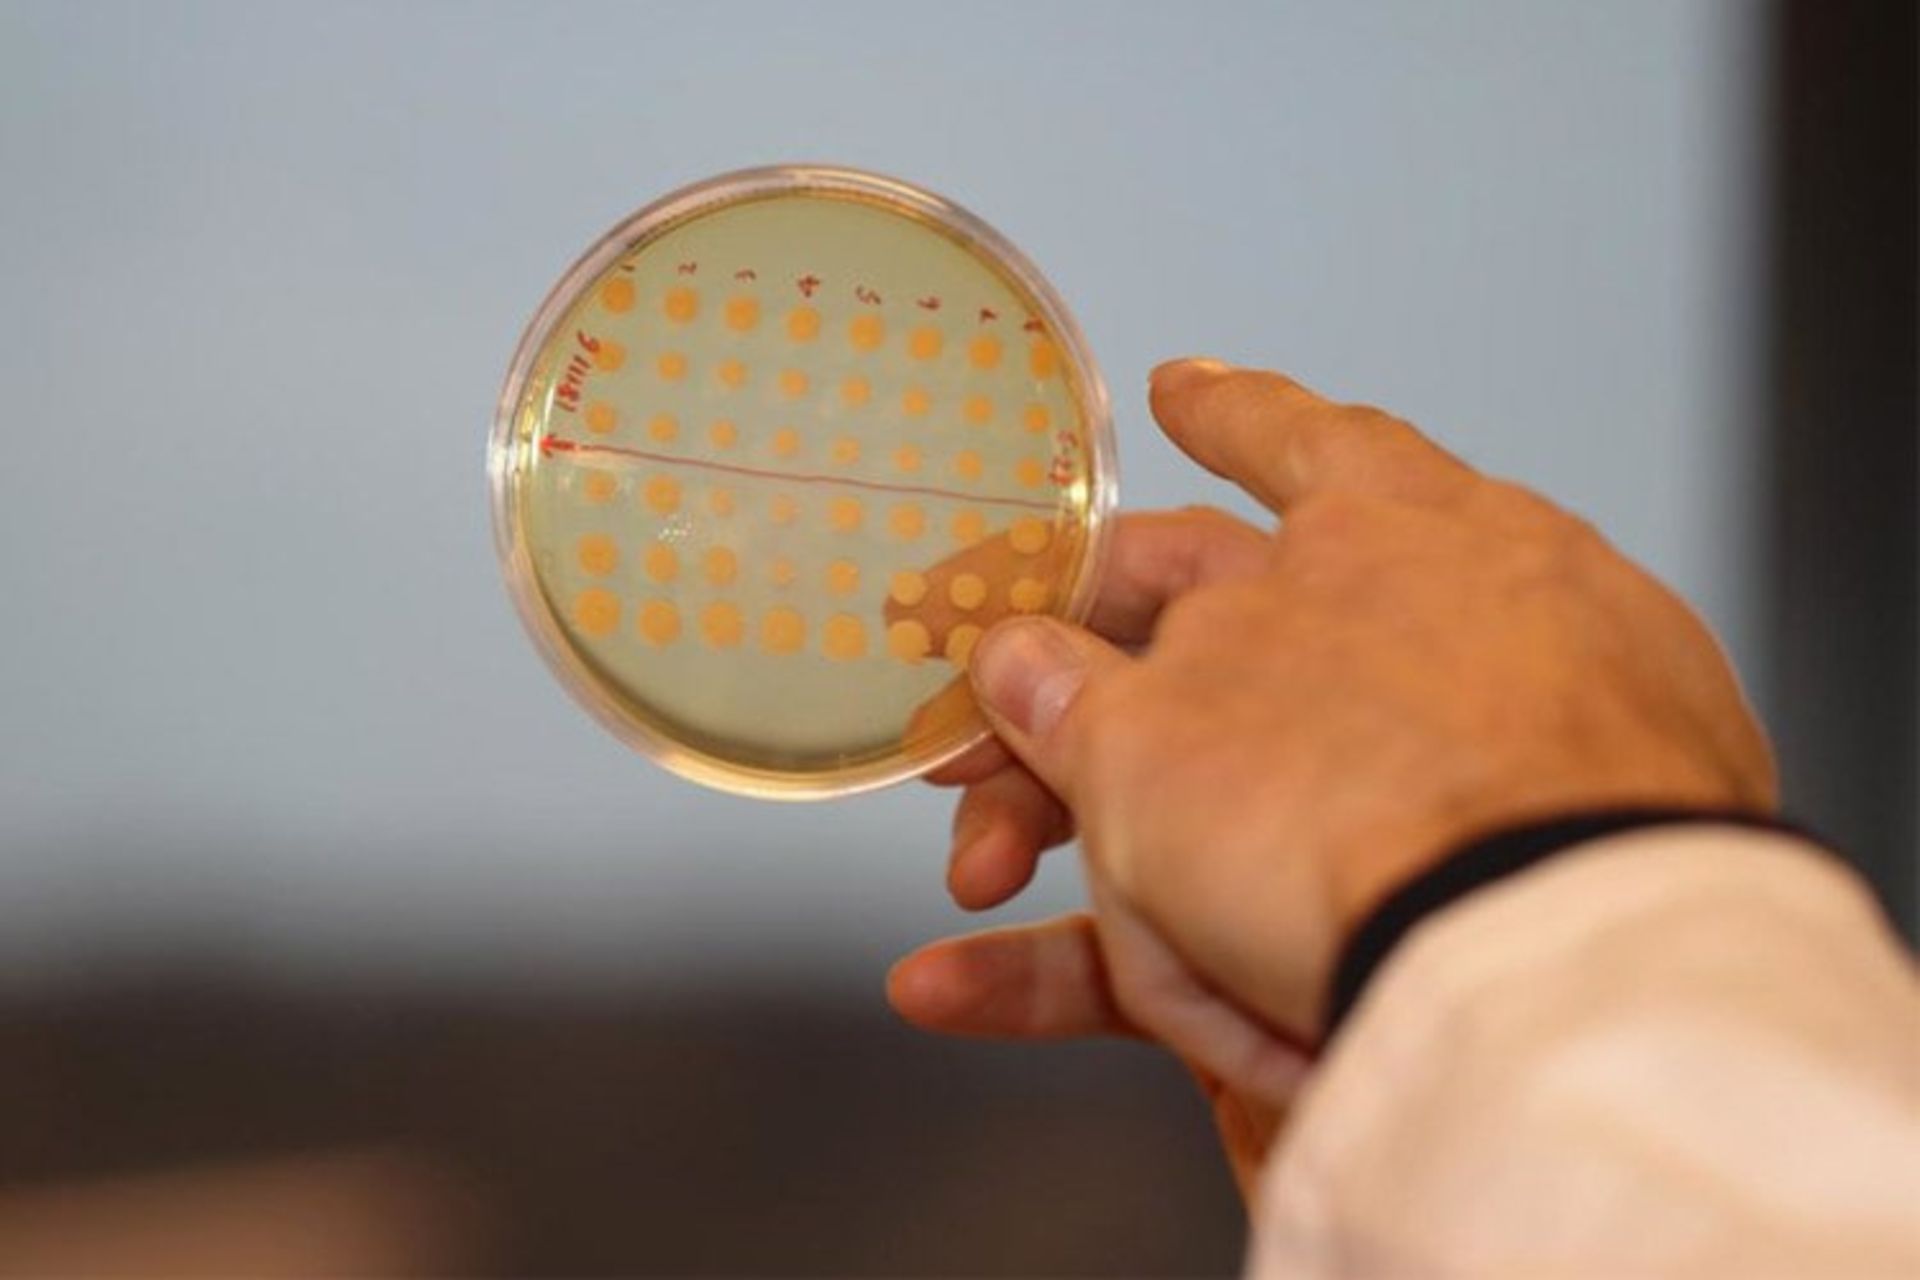

کوشش دانشمندان برای تولید داروهای ضدسرطان به کمک مخمر
طبیعت چنان پیچیده است که مولکولهای طبیعی را که برای درمان سرطان بهکار میروند، هنوز نمیتوان از راه سنتز شیمیایی تولید کرد. امروزه، شرکتهای شیمیایی و دارویی مقادیر زیادی از گیاهان و بذرها را بهمنظور استخراج مواد ارزشمند برداشت میکنند. بااینحال، روشهای تولید مبتنی بر عصارههای طبیعی ازلحاظ زیستمحیطی مشکلساز است و اغلب به تولید ضایعات شیمیایی زیادی منجر میشوند.
علاوهبراین، خطر انقراض گیاهان نادر نیز وجود دارد. اخیرا با وضع مقررات جهانی درزمینهی حمایت از تنوع زیستی و موادخام در کشورهای جهان سوم، موضوع ضرورت دستیافتن به روشهای تولید جدید و پایدار برای این نوع داروها مطرح شده است. یکی از پژوهشگران مرکز بنیاد نوو نوردیسک میگوید:
باتوجهبه قوانین جدید، اگر بخواهیم در آینده داروهایی برای بیماران سرطانی یا افراد مبتلا به مشکلات روانی تولید کنیم؛ باید راه جایگزین مناسبی بیابیم.

راولفیا سرپنتینا ممکن است راهحل باشد
در بسیاری از مواقع، این مواد شیمیایی گیاهی بسیار پیچیده را نمیتوان مانند مواد دارویی شیمیایی معمولی تولید کرد. برای تولید این نوع مواد به فرایندی بیوکاتالیزوری نیاز است. پروژهی پژوهشی بزرگی با عنوان MIAMi درحالراهاندازی است که هدفش معرفی مسیری جایگزین برای تولید این داروها با استفاده از مخمر نانوایی است. در ابتدا، پژوهشگران قصد دارند مسیرهای بیوسنتز گیاه راولفیا سرپنتینا را نقشهیابی کنند. در طب سنّتی چینی، آمده است که گیاه راولفیا سرپنتینا ملکولهایی با خاصیت ضدسرطانی تولید میکند. تولید این ترکیبات ارزشمند در خارج از گیاه هنوز ممکن نیست؛ زیرا مسیرهای بیوسنتز آن در گیاه ناشناخته ماندهاند. مسیر بیوسنتز، تعدادی از ژنهای خاص و کدکنندهی آنزیمهایی هستند که زیستملکول را درون سلول میسازند. با کسب دانش دربارهی ریشهی ژنتیکی محصول، این ژنها را برای تولید مولکول مدنظر میتوان وارد مخمر کرد. درواقع هدف نهایی، واردکردن ژنها درون سلولهای مخمر است تا بهعنوان کارخانههای مولکولی مقادیر زیادی از این مواد دارویی خاص را تولید کنند.
یکی از شرکاری MIAMi، شرکت شیمیایی فرانسوی بهنام Axyntis است که سالانه صدها تن از بذر گیاهانی، همچون وواکانگا آفریکانا را برای تولید داروهایی نظیر تابرسونین وارد میکند. بااینحال، مقررات جدید این روش تولید دارو را در آینده محدود خواهد کرد. مایکل کروگ جنسن میگوید:
صنعت میداند لازم است تغییر کند و این مقررات علامتی آشکار در اینباره هستند. انتظار نداریم این محصولات را طی دورهی این پروژه بتوانیم تولید کنیم؛ بهطوریکه بتوانند با محصولات موجود رقابت کنند. باوجوداین، مشخص است در آینده شرکتها نمیتوانند این نوع داروها را به بیماران عرضه کنند.
با این وضعیت، ضرورت کشف مولکولهای طبیعی جدید دارای فعالیت علیه برخی از بیماریهای رایج، نظیر سرطان و بیماریهای روانی، مانند اسکیزوفرنی آشکار است و پژوهشگران این پروژه در دورهی چهارسالهی آن قرار است قدمهایی در مسیر کشف و تولید این مولکولها بردارند.